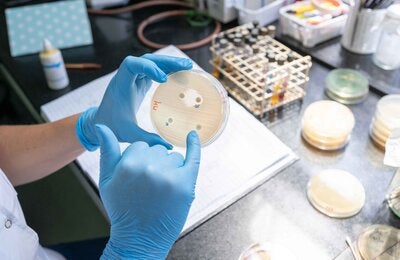
La imagen muestra la detección de mecanismos de resistencia utilizando un método manual.

La resistencia a los antimicrobianos (RAM) representa una amenaza sanitaria global creciente, que debe ser abordada con urgencia en la salud humana, la producción animal, agrícola y el medio ambiente porque pone en riesgo el tratamiento eficaz de infecciones causadas por bacterias, parásitos, virus y hongos, lo que resulta en enfermedades más prolongadas y mayor mortalidad. El impacto es mayor en las poblaciones más vulnerables. A su vez, la RAM pone en riesgo la sostenibilidad de los sistemas agroalimentarios y con ello la seguridad alimentaria.
Desde 2010, existe un firme compromiso de la Organización de las Naciones Unidas para la Alimentación y Agricultura (FAO), la Organización Mundial de Sanidad Animal (OMSA) y la Organización Panamericana de la Salud (OPS) para combatir la RAM, trabajando de forma coordinada para mitigar los riesgos en la interfaz salud humana, animal y del medio ambiente. Bajo este contexto, las tres organizaciones han aunado fuerzas para la implementación del proyecto “Trabajando juntos para combatir la resistencia a los antimicrobianos” bajo el enfoque de Una Salud que reconoce la multidimensionalidad y la necesidad de una respuesta intersectorial que exige este problema.
El objetivo estratégico general de este proyecto (2020-2022) apoyado y financiado por la Unión Europea (UE), es apoyar los esfuerzos para combatir la resistencia a los antimicrobianos a través de la implementación de los Planes de Acción Nacional de siete países: Argentina, Brasil, Chile, Colombia, Paraguay, Perú y Uruguay.